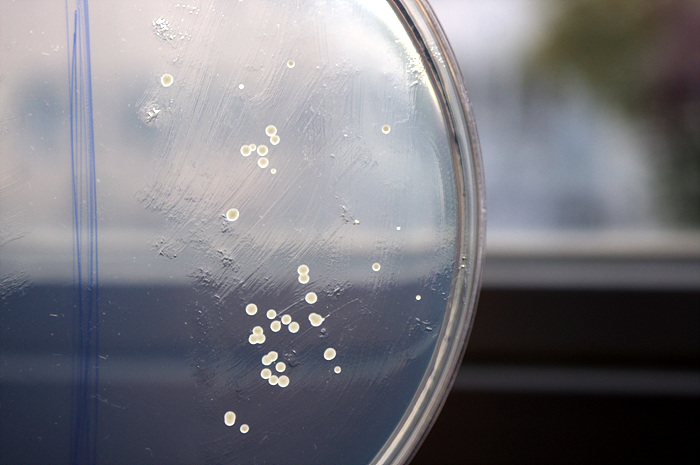
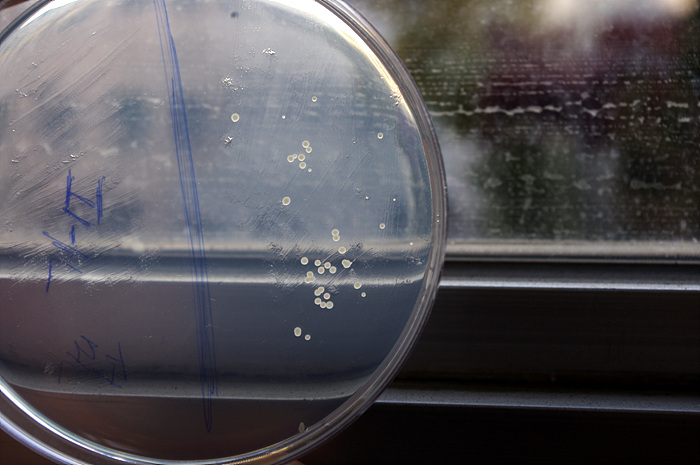
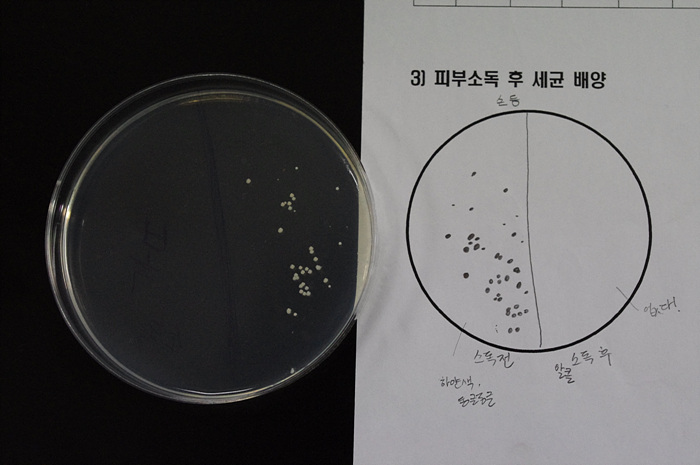
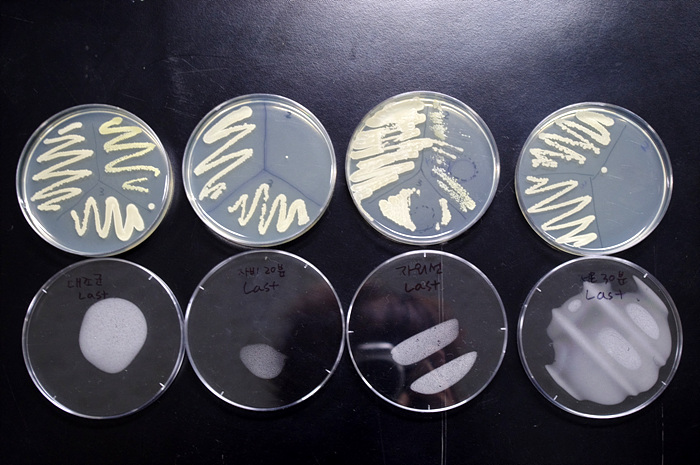
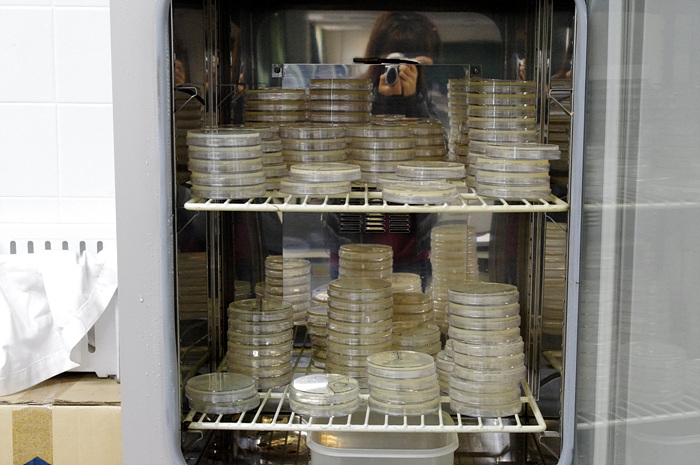
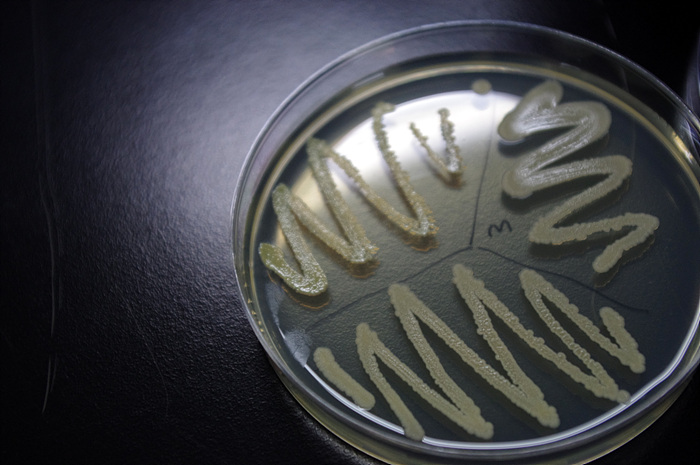
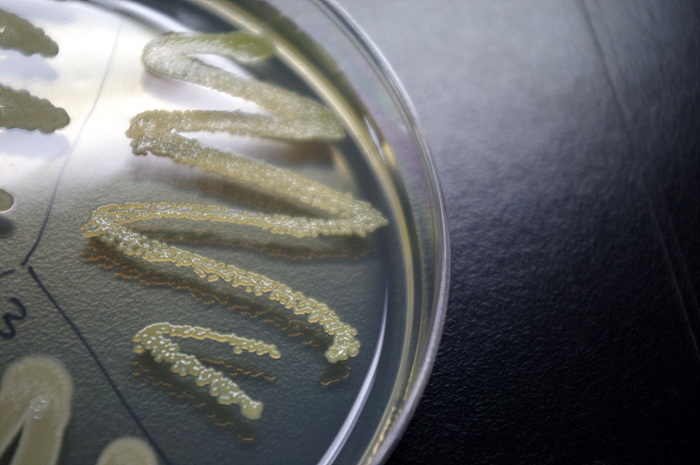
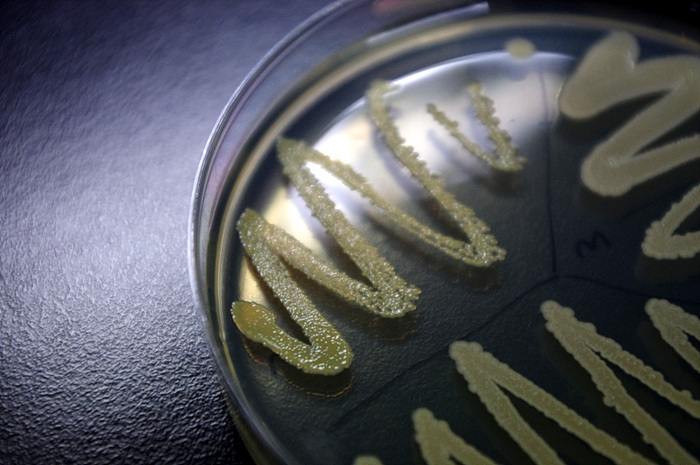

PENTAX K-r | Aperture Priority | 55.00mm | ISO-200 | F8.0 | 1/100s | 0.00 EV | Spot | Auto WB | 2010-11-11 08:31:42
PENTAX K-r | Aperture Priority | 42.50mm | ISO-200 | F8.0 | 1/100s | 0.00 EV | Spot | Auto WB | 2010-11-11 08:31:28
PENTAX K-r | Aperture Priority | 40.00mm | ISO-3200 | F8.0 | 1/80s | 0.00 EV | Spot | Auto WB | 2010-11-11 08:39:24
PENTAX K-r | Aperture Priority | 40.00mm | ISO-800 | F6.3 | 1/8s | -1.00 EV | Spot | Auto WB | 2010-11-11 08:50:19
PENTAX K-r | Aperture Priority | 37.50mm | ISO-3200 | F8.0 | 1/20s | 0.00 EV | Spot | Auto WB | 2010-11-11 08:26:31
PENTAX K-r | Aperture Priority | 37.50mm | ISO-800 | F4.5 | 1/60s | 0.00 EV | Spot | Auto WB | 2010-11-11 08:44:49
PENTAX K-r | Aperture Priority | 55.00mm | ISO-800 | F5.6 | 1/30s | 0.00 EV | Spot | Auto WB | 2010-11-11 08:52:51
PENTAX K-r | Aperture Priority | 42.50mm | ISO-1600 | F4.5 | 1/80s | 0.00 EV | Spot | Auto WB | 2010-11-11 08:44:55
회원정보
아이디 : oyez
닉네임 : 추억을크로핑하다
포인트 : 184306 점
레 벨 : 최우수회원(레벨 : 6)
가입일 : 2009-11-18 15:12
포토앨범보기 쪽지보내기